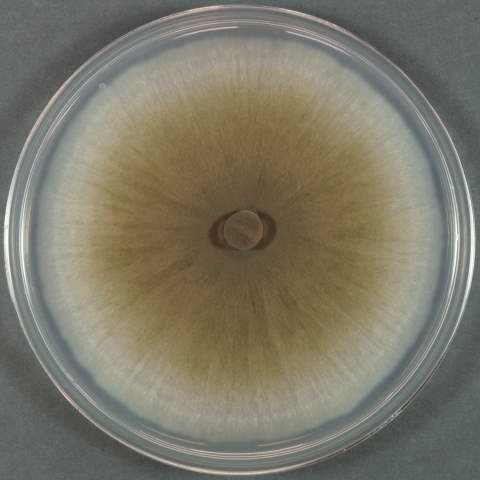
JCM22320A.jpg

술과 생물자원 보존
곰팡이 이야기(2) - 60년 격동의 시대를 넘어 환상의 술 부활
지난주에 백국균에 대하여 이야기를 했는데 이번에는 백국균의 어미뻘인 흑국균에 대한 에피소드 하나 소개합니다.
2006년 9월 농업생물자원 관리 연수를 위하여 일본의 NBRC(NITE Biological Resources Center, 경제산업성 생물자원센터)를 방문한 적이 있었다. 1주일간의 연수를 마치고 귀국하는 날, NBRC 소장 Kenichiro Suzuki 박사는 나를 본인 모교인 동경대학교에 데리고 가서 술 한병을 사주었다. 그리고 그 술(御酒)에 대한 사연을 들려주었는데,

<그림 1. NBRC 소장 Kenichiro Suzuki 박사가 선물한 아와모리 소주>
1935년. 동경대학교의 술박사 사가구치(坂口) 교수는 소주 생산을 위한 유용 균주 확보를 위하여 오키나와의 68개 아와모리(泡盛) 제조사를 방문하여 아와모리 제조용 흑국균 620균주를 수집하고 연구, 보존하였다.
1944년. 2차 세계 대전 후반 미국의 동경(東京) 공습이 격화되자 사가구치 박사는 수집한 주요 흑국균을 본인의 고향인 니이가타(新潟)현에 중복 보존한다.
1945년. 오키나와 전투에서 아와모리를 생산하는 공장들이 모인 슈리성(首里城)지역이 철저하게 파괴되고 아와모리 주조소(酒造所)들도 전소되었다. 2차대전이 끝나고 오키나와가 미군의 통치를 받게 됨에 따라 오키나와는 한 동안 아와모리 생산이 중단되었고 고유의 흑국균도 역사 속으로 사라져 버렸다.
1998년. 동경대학교 분자세포생물학연구소의 미생물은행(IAM)에 14개 아와모리 주조소의 19균주의 흑국균이 보존되어 있다는 사실이 공개된다. 전전(戰前)의 14개의 아와모리 주조소 중에서 명맥을 유지하는 회사는 2개소. 이 중 서천주조(瑞泉酒造)는 전전 흑국균을 이용하여 예전의 술을 부활시키기로 결심한다.
(오키나와 전투와 미국의 오키나와 점령으로 아와모리 제조사들이 보유한 고유한 균주들은 대부분 사라지고 1990년대의 아와모리 제조사들은 아와모리형 균주 ISH1 (Asp. luchuensis)와 사이토이형 균주 ISH2(Asp. tubingesis) 두 균주를 조합하여 사용하고 있었다.)

< 그림 2. 격동의 세월을 지나 부활한 균, JCM 22320>
1999년. 서천주조의 흑국균(JCM 22320, 瑞泉菌)은 64년만에 오키나와 수리성으로 귀향하고 옛 술의 복원작업이 시작되었다. 오랫동안 동결건조 앰플에서 잠들어 있던 서천균은 처음 배지상에 접종하였을 때에 다행히 균사는 자랐으나 포자를 형성하지 않아 술 복원이 불가한 것으로 판단되었다. 하지만 이들을 아와모리 제조 원료인 쌀에 직접 접종하였을 때에 고유의 검은 색깔의 포자를 만들었고 충분한 산(酸)을 생성하여 주조가 가능한 것으로 판단되었다.
1999년 6월 1일. 격동의 세월을 넘어 환상의 술 부활. 백매화향이 나며 달고 부드러운 맛을 가진 어주(御酒,うさき)는 생물자원 관리에 대한 과학자의 열정과 과학 기술의 덕분으로 부활하였다.
농촌진흥청 국립농업과학원 농업미생물은행(KACC, Korean Agricultural Culture Colleciton)은 메주, 누룩 등의 전통 식품재료로부터 사라져가고 있는 고유 미생물을 발굴, 수집하여 국가자원으로 등록, 영구 보존하며 연구자들에게 제공하고 있습니다.
< 그림 3. 농업미생물은행(KACC)의 액체질소보존 탱크, 전통식품분리 토착 미생물이 보존되고 있다.>
<참조>
- 어주의 기원에 대하여 안내하고 있는 서천주조 홈페이지